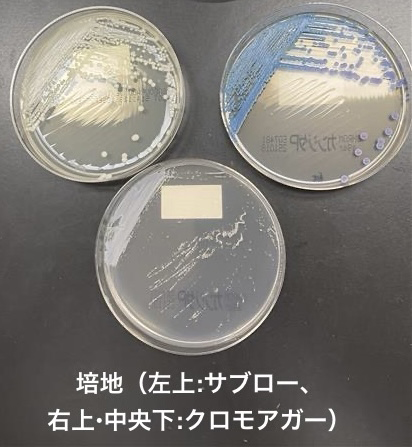

microbiology round
先日のMicrobiology roundではCryptococcus neoformansを取り上げました。
【歴史】(1)
• 分類:Basidiomycota門、Tremellomycetes網、Tremellales目、Cryptococcaceae科、Cryptococcus属
• 1894年:Sanfeliceが桃ジュースからCryptococcusを同定した。
• 1895年:BusseとBuschkeがヒトでの初報告(若年女性の脛骨上部慢性潰瘍で酵母菌を確認)。
• 当初はSaccharomyces neoformans、Cryptococcus hominis、Torula histolyticaなど複数の名称が使用されたが、1950年にBenhamがCryptococcus hominisと命名し、疾患名を「クリプトコッカス症」とした。その後Sanfeliceの種名使用に基づきCryptococcus neoformansに変更された。
• 2002年にはC. neoformans var. neoformans(血清型D)、C. neoformans var. grubii(血清型A)、およびC. gattii(血清型B・C)が提案された。
【疫学】(2)
• 1955年以前の報告は約300例であったが、HIV感染者の増加に伴い症例数は劇的に増加した。
• 2022年報告:CD4数<200/μLのHIV陽性者では約15.2万人がクリプトコッカス髄膜炎を発症し、約11.2万人が死亡。これは世界のAIDS関連死亡の約20%に相当する。
【微生物学的特徴】(1,3,4)
• 顕微鏡:球形〜卵円形の酵母様真菌である。墨汁法により、厚い莢膜をもつCryptococcus属は菌体周囲に透明なハローが観察される。継代培養により莢膜は薄くなる(3)。
• 生化学的特徴:
o ウレアーゼ産生能をもち、カンジダなど他の酵母様真菌と区別可能である。
o メラニン産生能(カテコールアミン由来、ラッカーゼ活性)により、病原因子として作用する。
o C. neoformansとC. gattiiはカナバニン・グリシン・ブロモチモールブルー (CGB) 寒天培地で識別可能であり、C. gattiiはL-カナバニン存在下で青色コロニーを形成する。
• 遺伝子解析技術により、菌株間のばらつきや種の細分化が明確化され、迅速かつ正確な同定が可能となった。
• 日常検査では薬剤感受性検査を行わないことが多い。理由として、第一選択薬耐性が臨床上大きな問題にならないこと、アゾールやアムホテリシンBに対するin vitro感受性検査の方法やブレイクポイントが十分に検証されていないことが挙げられる(3)。
【感染経路】(4)
• 世界中の土壌に存在し、ヒトの常在菌ではない。
• ヒトからヒト感染は基本的にないが、臓器移植由来の感染例が報告されている。動物への感染例もあるが、人獣共通感染は稀である(4)。
• 感染経路は主に吸入である。感受性宿主が感染性散布体を吸入すると肺胞で酵母がマクロファージと接触し、Th1反応と肉芽腫性炎症を誘発する。その後、以下のいずれかの経路を辿る:
1. 免疫抑制患者:増殖・播種 → 臨床症状発現
2. 効果的な免疫応答:完全排除
3. 肺リンパ節複合体に休眠 → 後に増殖・播種
• 健康成人では曝露率約5%、鳩飼育者など高リスク群では二桁%に達する(4)。
【リスク因子】(5)
• HIV感染、固形臓器移植、その他の細胞性免疫異常。
• 既知の免疫不全がない場合は、HIV抗原抗体検査、IFN/GM-CSF自己抗体、特発性CD4減少症など二次性免疫不全の評価が必要である(5)。
【臨床症状】(4,5)
• 主に中枢神経系(CNS)および肺に感染するが、皮膚、前立腺、腹膜、眼なども感染可能である。
• C. gattiiは孤立性肺感染が多く、C. neoformansはCNS感染が多い(4,5)。
【クリプトコッカス髄膜炎】
• 症状:頭痛、精神状態変化、吐き気、視覚障害、外転神経麻痺、聴覚障害(4,5)
• 頭蓋内圧上昇のメカニズム:
1. 莢膜多糖の透圧作用でCSF粘稠度上昇
2. 菌体・莢膜成分によるCSF排出阻害
3. 大きな菌塊による脳実質mass effect(5)
【髄液検査】(6–11)
1. 一般検査:慢性髄膜炎パターン。HIV患者では反応が弱く、細胞数・蛋白・糖の変化が少ないことがある(6)。
2. 初圧:AIDS患者の約70%で20cmH2O以上。非HIV患者では頭蓋内圧亢進はそれほど多くみられない(7)。
3. 墨汁法:HIV患者約75%、非HIV患者約50%で莢膜酵母を確認(8)。
4. 髄液培養:少なくとも3-5mL、可能なら15mL以上で感度向上(7)。
5. 髄液クリプトコッカス抗原(GXM):酵母存在の確認に有用(6)。
6. PCR(FilmArray®髄膜炎・脳炎パネル):特異度高いが感度は疑問が投げかけられている。high-volume LP (10mL採取)で診断精度が向上した報告がある(9,10,11)。
【治療】(12)
• 中枢神経型、全身性型、肺単独型、皮膚への直接接種型で治療が異なる。治療経過中の髄液検査異常は必ずしも治療失敗を示さない。
クリプトコッカス髄膜炎治療
1. 抗真菌薬
o L-AMB + 5-FC併用で最短2週間(重篤な神経学的合併症、画像所見、基礎疾患、治療反応により延長)
o 初期治療終了後、FLCZによる8週間のConsolidation治療、さらにFLCZによる維持治療として1年間
2. 頭蓋内圧管理
o CSF圧25cmH2O以上で症状がある場合は排液し50%低下か、正常圧である20cm H2O以下に。通常20-30mL必要になる。
o 毎日繰り返し2日以上安定するまで続ける必要がある。経皮的ドレナージや脳室シャントも検討。
o IRISを伴わない頭蓋内圧亢進でコルチコステロイドは一般的に有用ではないとされている。
3. 免疫抑制調整
o 感染制御までイブルチニブなどの免疫抑制剤を中止
o 免疫抑制療法の減量によるベネフィットと臓器拒絶反応および免疫再構築の可能性とのバランスを取る必要がある
【予後】(1)
• 最も重要な予後因子は基礎疾患の管理である。
• 癌患者はHIV患者より生存期間が短い。
• 墨汁検査強陽性、多糖体抗原価高値(≥1:1024)は予後不良を示唆する。
• 先進国では即時死亡率(6ヶ月から1年後)10-25%、発展途上国では6ヶ月後の死亡率は50-100%に達する場合がある。
【参考文献】
1. Perfect JR, Boulware DR. Mandell, Douglas, and Bennett’s Principles and Practice of Infectious Diseases. 3148-3165.e6.
2. Rajasingham R, et al. Lancet Infect Dis. 2022;22(12):1748–55.
3. Perfect JR, et al. Clin Infect Dis. 2010;50(3):291–322.
4. Meya DB, Williamson PR. N Engl J Med. 2024;390(17):1597–610.
5. Jani A, et al. Infect Dis Clin North Am. 2025;39(1):199–219.
6. Ngan NTT, Flower B, Day JN. Drugs. 2022;82(12):1237–49.
7. UpToDate. Clinical manifestations and diagnosis of Cryptococcus neoformans meningoencephalitis in patients without HIV. 2025. [cited 2025 Sept 19]
8. Saag MS, et al. N Engl J Med. 1992;326(2):83–9.
9. Rhein J, et al. Diagn Microbiol Infect Dis. 2016;84(3):268–73.
10. O’Halloran JA, et al. Open Forum Infect Dis. 2017;4(4):ofx242.
11. Tansarli GS, Chapin KC. Clin Microbiol Infect. 2020;26(3):281–90.
12. UpToDate. Treatment and prevention of meningoencephalitis and disseminated infection in patients without HIV. 2025. [cited 2025 Sept 19]

このサイトの監修者
亀田総合病院
臨床検査科部長、感染症内科部長、地域感染症疫学・予防センター長 細川 直登
【専門分野】
総合内科:内科全般、感染症全般、熱のでる病気、微生物が原因になっておこる病気
感染症内科:微生物が原因となっておこる病気 渡航医学
臨床検査科:臨床検査学、臨床検査室のマネジメント
研修医教育